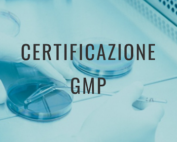

Cos’è la certificazione GMP? Ottenetela con BQS
La certificazione GMP – Norme di Buona Fabbricazione (Good Manufacturing Practices) – stabilisce le condizioni operative e i requisiti necessari per garantire l’igiene in tutta la catena alimentare e per la produzione degli alimenti stessi. [...]
Cantine vinicole e HACCP: come si agisce?
La cantina vinicola, dove viene cioè prodotto il vino, può essere assimilata a un’azienda agricola dal punto di vista delle procedure HACCP, che vanno rispettate per garantire la sicurezza dei prodotti. Il vino per sua [...]
Tutto sulla RSI: vi spieghiamo cos’è e a cosa serve
La Responsabilità Sociale dell’Impresa (RSI) é un’opportunità di crescita rispettosa di società e ambiente per tutte le aziende, dalle piccole alle medie sino a quelle di grandi dimensioni. Essa riguarda l’impatto sociale ed ambientale delle [...]
I vantaggi della nuova ISO 22000 per l’alimentare
La nuova versione dello standard ISO 22000 contiene una serie di modifiche introdotte per aumentare la leggibilità e la chiarezza dei processi e per spiegare in modo più approfondito i concetti chiave dei CCP (Critical [...]
Un comune moderno e vicino ai cittadini grazie alla ISO 9001!
Ottnere la certificazione in questione è un progetto intercomunale nel Mendrisiotto. La nostra società riveste un ruolo importante nella sua pianificazione e nella sua gestione. Per un Comune ticinese ottenere e mantenere la certificazione di [...]
Assieme a BQS, un successo per Matasci e Cagi Cantina!
È con molto piacere ed un pizzico di orgoglio che comunichiamo l’ottenimento dell’importante certificazione, non facile da raggiungere, UNI EN ISO 22000:2005, per le cantine Matasci Vini SA e la Cagi Cantina Giubiasco SA. Essa [...]